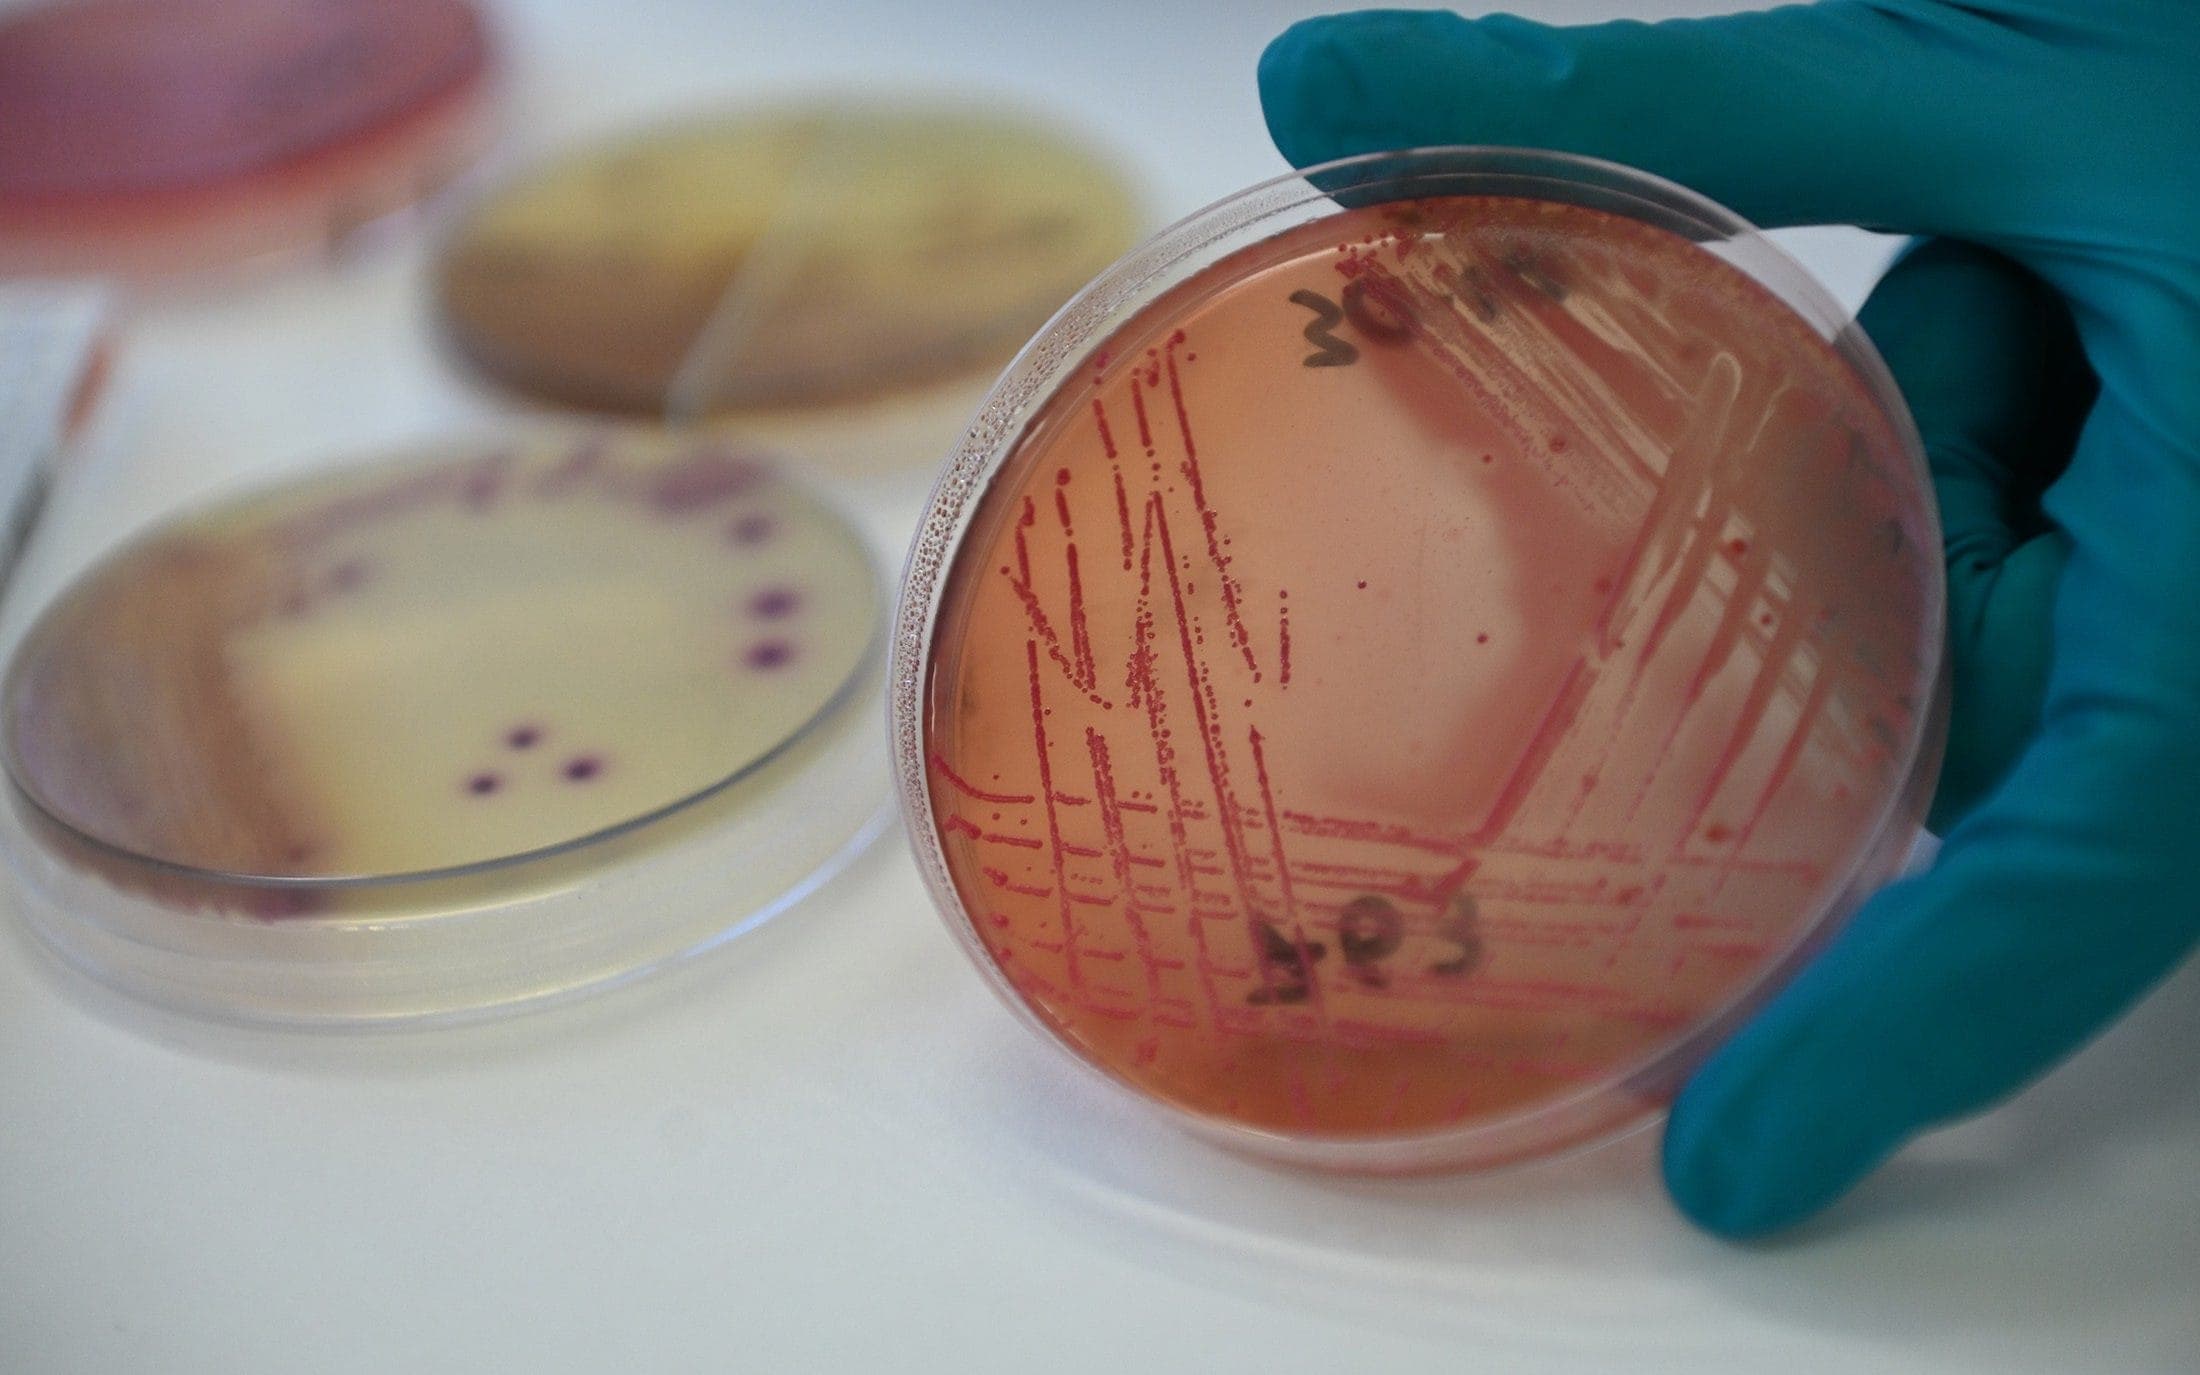
Fightback: scientists score series of wins in battle against superbugs

Originally published byThe Telegraph
Recent scientific breakthroughs fuel optimism that the pace of drug discovery is picking up again
🇬🇧
More news from United KingdomUnited Kingdom
EUROPE
Related News

Starmer to back Budget after Reeves accused of misleading public
6d ago

'Too scared to speak' - Nigerian villagers on living in the midst of kidnap gangs
November 30, 2025
🇩🇪
White House launches tracker to call out 'media offenders'
6d ago

The five things that set the 2025 Atlantic hurricane season apart
November 30, 2025
Drinking is a way of life in Ireland. Can a warning label change that?
November 30, 2025